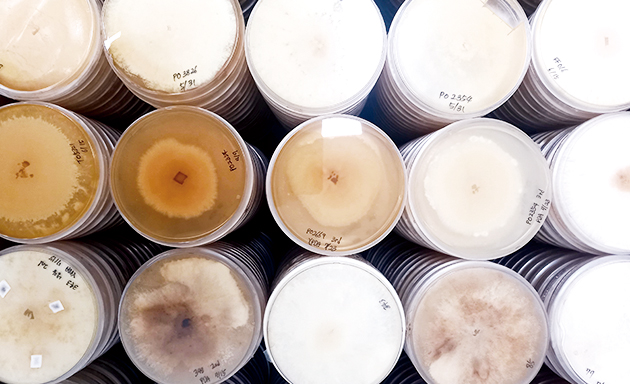

Гроші підуть на комерціалізацію штучної шкіри на основі міцелію у 2023 році.
«Ми використаємо це нове фінансування, щоб відкрити виробничий завод у Південній Кореї, і подвоїти його штат до 42 працівників», – коментує колишній співробітник Hyundai Motor Сунгджін Сах.
Mycel використовує міцелій для створення замінників шкіри, які можна використовувати для автомобільних сидінь, косметики високого класу та модних речей, таких як взуття, одяг і сумки.
На веб-сайті зазначено, що компанія «розробляє та випробовує нову естетику».

З 2000 року HMG керує внутрішньою венчурною системою, щоб дати співробітникам Hyundai Motor Company та Kia, які мають інноваційні ідеї, можливість комерціалізувати їх.
У 2017 році охоплення групи розширилося, щоб залучити всіх співробітників HMG. Вона постійно обирала та запускала кілька внутрішніх ініціатив для відкритих інновацій у сферах мобільності, автомобільних компонентів, програмного забезпечення та ІТ-послуг.
У 2016 році Mycel почав як учасник внутрішньої програми підтримки стартапів HMG з розробки матеріалів, таких як транспортні композити та тканини на основі міцелію. А у травні 2020 року HMG оголосила, що Mycel відокремилася як незалежна компанія.

Mycel планує комерціалізувати грибну шкіру в Сінгапурі
Також вона веде переговори з міжнародними косметичними брендами щодо спільної розробки шкіряних виробів на основі міцелію та косметичних інгредієнтів.

До слова, раніше HMG також об’єднала зусилля з Uber Eats для доставки їжі безпілотними автомобілями.
Джерела: Mycel, Vegconomist

